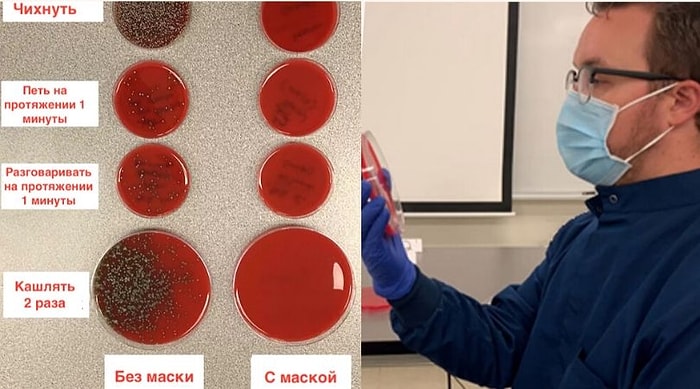
Ученый продемонстрировал защитные свойства маски с помощью эксперимента

Homepage Новости
Все новости, контент, галереи, тесты и видео о Homepage — в Onedio. Вы можете следить за последними новостями и событиями в области Homepage и новым контентом на этой странице.








Популярные Статьи













- 1
- ...
- 255

Все новости, контент, галереи, тесты и видео о Homepage — в Onedio. Вы можете следить за последними новостями и событиями в области Homepage и новым контентом на этой странице.